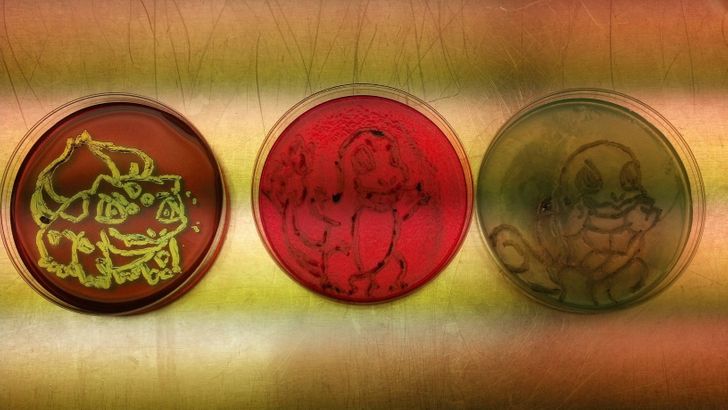

20 odaadó ember, aki 101%-ot ad bele munkájába
Hacsak nem gazdag családba születünk akkor bizony mindannyiunknak dolgoznunk kell, hogy megkeressük a mindennapi kenyerünket. De a nap végén mindenféle emberek vannak, akik azon kapják magukat, hogy egy kis pluszt adnak, mikor megpróbálják jól végezni a munkájukat.
Szeretnénk tisztelegni mindazok előtt, akik a mindennapi munkájuk során felnőnek a feladathoz (különösen, ha mindezt humorral teszik), ezért megosztjuk veletek ezeket a példákat.
A szálloda személyzete ezt a törülköző állatot hagyta itt nekem.

Ez az iráni tanár naponta meglátogatja az egyik diákját, hogy segítsen a pótolásban.

Mentő vitt el egy háromgyerekes anyukát, és két rendőr ott maradt, hogy vacsorát készítsen a gyerekeknek. Utána el is mosogattak.

Mint egy zen kert!

Mikor túl kedves a dolgozó.. 2000-ben vásárolt pólót cseréltek vissza 17 évvel később.

Francia hagymaleves, hatalmas hagymában tálalva.

Mikor a matektanárt átjárja az ünnepi hangulat.

15 dollárt fizettem ezért a „reggeli tárcáért”.

Mindennek megvan a maga helye!

Mindent azért, hogy tisztán tartsa az ételeket!

Az éjszakai műszak alatt volt időm rendet rakni..

Bébiszitterhez adtuk a kutyánkat, míg nyaraltunk. Naponta fotókkal bizonyította, hogy minden rendben van..

Bulbasaur, Charmander és Squirtle – baktériumokból kirajzolva!
Miután a párom kiborította az italát, a pincérnő ezt hozta ki.

Japánban minden élet biztonságára odafigyelnek!

Órára jövet megmentett egy kiscicát..

Igyunk az összes tűzoltóra, akik mindent beleadnak.

Végre eltudtam rendezni a kábeleket!

Az iskolám könyvtárosa minden tanév végén „Könyv Kaszásnak” öltözik, hogy összegyűjtse a könyveket..

Viccből kértem egy Nicholas Cage képet a szállodai szobámba.. Túlteljesítették a kérést..




via: brightside.me
